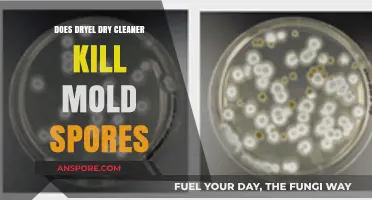
Dryel Dry Cleaner: Effective Mold Spores Killer or Not?

Ringworm, a common fungal infection caused by dermatophytes, can be a persistent issue due to its ability to spread and survive in various environments. One question often raised is whether daylight, specifically ultraviolet (UV) radiation from the sun, can effectively kill ringworm spores. While sunlight is known to have antimicrobial properties and can reduce the viability of certain fungi, its effectiveness against ringworm spores is not fully established. UV radiation can damage the DNA of fungi, potentially rendering them inactive, but factors such as intensity, duration of exposure, and the specific species of dermatophyte involved play significant roles. Additionally, ringworm spores are resilient and can survive in dark, humid environments, making sunlight exposure alone an unreliable method for eradication. Thus, while daylight may contribute to reducing spore viability, it should not be solely relied upon as a treatment or prevention strategy for ringworm.
| Characteristics | Values |
|---|---|
| Effect of Daylight on Ringworm Spores | Limited direct evidence; sunlight may reduce spore viability over time |
| UV Light Impact | UV-C light is effective in killing ringworm spores, but natural daylight has lower UV-C intensity |
| Temperature Influence | Higher temperatures in sunlight may contribute to spore inactivation |
| Duration of Exposure | Prolonged exposure (hours to days) may be needed for significant effect |
| Surface Type | Efficacy varies; spores on porous surfaces may be more resistant |
| Humidity Factor | Dry conditions in sunlight can reduce spore survival |
| Comparative Methods | Less effective than chemical disinfectants or UV-C lamps |
| Practical Application | Not a reliable standalone method for ringworm spore eradication |
| Scientific Consensus | Insufficient data to confirm daylight as a primary spore killer |
| Precautionary Advice | Use proven methods like antifungal treatments and thorough cleaning |
Explore related products
What You'll Learn
- UV Light Intensity: Effectiveness of different UV levels on ringworm spore destruction
- Exposure Duration: Time required for daylight to eliminate ringworm spores
- Surface Materials: How various surfaces impact spore survival in daylight
- Environmental Factors: Role of humidity and temperature in spore inactivation
- Spore Resistance: Comparative resilience of ringworm spores to sunlight exposure

UV Light Intensity: Effectiveness of different UV levels on ringworm spore destruction
Ultraviolet (UV) light is a known disinfectant, but its effectiveness against ringworm spores hinges on intensity and exposure time. UV-C light, the most germicidal type, operates at wavelengths between 200–280 nanometers, with peak efficacy around 254 nm. Studies show that UV-C at 1,000 μW/cm² can inactivate 90% of *Trichophyton* spores—the fungus causing ringworm—in 15 minutes. However, lower intensities, such as 500 μW/cm², require double the exposure time for similar results. This highlights the inverse relationship between UV intensity and treatment duration, a critical factor for practical applications like disinfecting surfaces or air in veterinary clinics or gyms.
When considering UV-B light (280–315 nm), its effectiveness against ringworm spores is significantly reduced. UV-B primarily targets DNA but lacks the energy to penetrate the spore’s protective layers effectively. Research indicates that even at high intensities (e.g., 1,500 μW/cm²), UV-B fails to achieve more than 50% spore inactivation after 30 minutes. This makes UV-B impractical for ringworm control, despite its use in treating skin conditions like psoriasis. For spore destruction, UV-C remains the superior choice due to its higher energy and deeper penetration capabilities.
Practical implementation of UV-C for ringworm spore destruction requires careful consideration of safety and dosage. Prolonged exposure to UV-C can damage human skin and eyes, so automated systems or unoccupied spaces are ideal. For example, a UV-C lamp emitting 254 nm at 1,000 μW/cm² can effectively disinfect a 100 sq. ft. room in 20 minutes, provided no one is present. Portable UV-C devices are available for targeted use, such as treating pet grooming tools or wrestling mats, but users must follow manufacturer guidelines to avoid overexposure. Always prioritize safety by using timers, remote activation, and protective gear.
Comparing UV-C to natural daylight reveals a stark contrast in efficacy. Daylight contains UV-A (315–400 nm) and minimal UV-B, neither of which possess sufficient energy to destroy ringworm spores. While sunlight can dry out surfaces and reduce fungal growth indirectly, it cannot reliably inactivate spores. For instance, leaving contaminated items in direct sunlight for hours may reduce spore viability slightly, but this method is inconsistent and far less effective than controlled UV-C treatment. Relying on daylight alone for disinfection is therefore not recommended for environments at high risk of ringworm transmission.
In conclusion, UV light intensity plays a pivotal role in ringworm spore destruction, with UV-C at specific wavelengths and dosages offering the most reliable solution. While UV-B and daylight fall short, UV-C’s ability to inactivate spores efficiently makes it a valuable tool in infection control. By understanding the relationship between intensity, exposure time, and safety, individuals and institutions can implement UV-C effectively to mitigate ringworm outbreaks. Always prioritize precision and caution when using UV-C technology to ensure both efficacy and safety.
Can Fungi Reproduce Without Spores? Exploring Alternative Reproduction Methods
You may want to see also

Exposure Duration: Time required for daylight to eliminate ringworm spores
Direct sunlight is a natural disinfectant, but its effectiveness against ringworm spores hinges on duration. Studies suggest that prolonged exposure to ultraviolet (UV) radiation, particularly UVB rays, can damage the DNA of fungal spores, rendering them unable to reproduce. However, the exact time required for complete eradication remains unclear and likely depends on factors like spore concentration, environmental conditions, and the intensity of sunlight.
While research is ongoing, preliminary findings indicate that several hours of direct sunlight may be necessary to significantly reduce ringworm spore viability. This highlights the potential of sunlight as a supplementary disinfection method, especially for contaminated surfaces or fabrics that can withstand prolonged sun exposure.
To maximize the antifungal potential of sunlight, consider the following practical steps:
- Direct Exposure: Place contaminated items in direct sunlight, avoiding shaded areas. Ensure all surfaces receive adequate UV exposure.
- Duration: Aim for a minimum of 4-6 hours of uninterrupted sunlight, ideally during peak UV hours (10 AM - 2 PM).
- Frequency: Repeat the process daily for several days to ensure thorough spore elimination.
- Material Considerations: Be mindful of fabric fading or damage from prolonged sun exposure.
It's crucial to remember that sunlight should not be solely relied upon for ringworm disinfection, especially in cases of severe infestation or on sensitive materials. Combining sunlight exposure with other proven methods like antifungal treatments or thorough cleaning is recommended for optimal results.
While sunlight offers a natural and accessible approach to combating ringworm spores, its effectiveness is time-dependent and influenced by various factors. By understanding the required exposure duration and implementing practical strategies, individuals can harness the power of sunlight as a complementary tool in their fight against ringworm.
Where to Buy Spore Key Registration: A Comprehensive Guide
You may want to see also

Surface Materials: How various surfaces impact spore survival in daylight
Direct sunlight is a known adversary of many fungal spores, including those of ringworm, but the battle isn't solely between light and spore. The surface on which these spores land can significantly influence their survival under daylight exposure. For instance, porous materials like wood or fabric can shield spores from the full brunt of UV radiation, allowing them to persist longer than on non-porous surfaces like glass or metal. This interaction between surface material and daylight efficacy is crucial for understanding how to combat ringworm spores in various environments.
Consider the practical implications for cleaning and disinfection. On smooth, non-porous surfaces such as countertops or tiles, a few hours of direct sunlight can drastically reduce spore viability. However, on carpeted floors or upholstered furniture, spores may remain viable for days, even with consistent daylight exposure. To maximize the germicidal effects of sunlight, prioritize moving items like rugs or cushions to sunny areas and ensure they receive at least 6 hours of direct light daily. For high-risk areas, combining sunlight exposure with a vacuum cleaner equipped with a HEPA filter can further minimize spore presence.
The material composition of surfaces also plays a role in spore survival. Dark-colored or UV-absorbent materials can reduce the intensity of sunlight reaching spores, inadvertently providing them with a protective environment. Conversely, light-colored or reflective surfaces, such as white tiles or aluminum, can enhance the effectiveness of daylight by increasing light reflection and exposure. When designing or selecting surfaces for spore-prone areas, opt for materials that amplify sunlight’s reach and intensity, especially in spaces like gyms, locker rooms, or pet areas where ringworm transmission is more likely.
A comparative analysis of surface materials reveals that while daylight is a powerful tool against ringworm spores, its effectiveness is not uniform across all environments. For example, spores on a wooden deck may survive up to 48 hours in sunlight, whereas those on a metal bench might perish within 4 hours. This disparity underscores the importance of tailoring disinfection strategies to the specific surfaces in question. Regularly rotating or flipping items like pet bedding or yoga mats can ensure even exposure, while using UV-reflective paints or coatings on walls and floors can create a more hostile environment for spores.
In conclusion, the interplay between surface materials and daylight exposure is a critical factor in controlling ringworm spore survival. By understanding how different materials affect spore persistence, individuals can adopt targeted strategies to enhance the natural germicidal properties of sunlight. Whether through material selection, strategic placement, or supplementary cleaning practices, leveraging this knowledge can significantly reduce the risk of ringworm transmission in both residential and public spaces.
How Mold Spores Spread: Understanding Airborne Contamination Risks
You may want to see also
Explore related products

Environmental Factors: Role of humidity and temperature in spore inactivation
Ringworm spores, or arthrospores, are notoriously resilient, capable of surviving for months in the environment. However, their longevity isn't absolute. Humidity and temperature emerge as critical environmental factors that can significantly influence spore inactivation. Understanding this interplay is crucial for developing effective strategies to combat ringworm transmission.
High humidity, generally above 70%, creates an environment conducive to spore survival. Moisture provides the necessary water activity for spores to remain viable. Conversely, low humidity, below 50%, can desiccate spores, rendering them inactive over time. This principle is leveraged in industrial drying processes to eliminate microbial contaminants.
Temperature plays a dual role in spore inactivation. Elevated temperatures, typically above 50°C (122°F), can directly kill ringworm spores through protein denaturation and membrane disruption. This is why heat treatment is a common method for sterilizing equipment and surfaces in veterinary and medical settings. However, prolonged exposure to moderate temperatures (25-35°C) coupled with high humidity can actually promote spore germination, increasing the risk of infection.
This delicate balance between humidity and temperature highlights the complexity of spore inactivation. Simply relying on sunlight, which primarily provides UV radiation, may not be sufficient. While UV light can damage spore DNA, its effectiveness is limited by factors like intensity, exposure time, and the presence of shading.
To effectively combat ringworm spores in the environment, a multi-pronged approach is necessary. Maintaining low humidity levels through proper ventilation and dehumidification is essential. In high-risk areas, such as animal shelters or gyms, regular cleaning with disinfectants effective against fungal spores is crucial. For surfaces that cannot be cleaned with chemicals, heat treatment using steam or dry heat can be employed. By understanding the interplay of humidity and temperature, we can create environments that are hostile to ringworm spores, ultimately reducing the risk of infection.
Are Ringworm Spores Airborne? Uncovering the Truth About Transmission
You may want to see also

Spore Resistance: Comparative resilience of ringworm spores to sunlight exposure
Ringworm spores, known as arthrospores, exhibit a surprising resilience to environmental stressors, including sunlight. Unlike many pathogens that succumb quickly to UV radiation, these spores can persist on surfaces for extended periods, even under direct sunlight. This tenacity is attributed to their thick cell walls, which act as a protective barrier against desiccation and radiation. Studies indicate that while sunlight can reduce spore viability over time, complete eradication often requires prolonged exposure—typically several hours of direct sunlight daily over multiple days. For instance, research shows that arthrospores can retain infectivity for up to 18 months in ideal conditions, though sunlight exposure significantly shortens this period to weeks or months, depending on intensity and duration.
To maximize the effectiveness of sunlight in combating ringworm spores, consider practical strategies. Place contaminated items, such as clothing or pet bedding, in direct sunlight during peak hours (10 a.m. to 4 p.m.), when UV rays are strongest. Rotate items periodically to ensure all surfaces receive equal exposure. For indoor environments, UV-C lamps can supplement natural sunlight, though these should be used cautiously to avoid skin and eye damage. Combining sunlight exposure with other disinfection methods, like washing items in hot water (60°C or higher) and using antifungal agents, enhances spore elimination. Note that while sunlight is a natural and cost-effective tool, it is not a standalone solution for severe infestations.
A comparative analysis of spore resilience reveals that ringworm arthrospores are more resistant to sunlight than many bacterial spores but less so than certain fungal species, such as *Aspergillus*. This middling resistance underscores the need for targeted approaches. For example, while 30 minutes of UV exposure might suffice to inactivate most bacterial spores, ringworm spores often require 2–4 hours of continuous sunlight to achieve similar results. This disparity highlights the importance of understanding the specific vulnerabilities of each pathogen. Pet owners and farmers, in particular, should be aware that outdoor environments, despite ample sunlight, can still harbor viable spores if exposure is inconsistent or brief.
From a persuasive standpoint, leveraging sunlight as a natural disinfectant is both eco-friendly and cost-effective, making it an ideal first-line defense against ringworm spores. However, reliance on sunlight alone can be risky, especially in regions with limited sun exposure or during winter months. In such cases, integrating artificial UV sources or chemical disinfectants becomes essential. For households with immunocompromised individuals or young children, who are more susceptible to ringworm infections, a multi-pronged approach is non-negotiable. Regularly cleaning and disinfecting high-touch surfaces, coupled with strategic sunlight exposure, can significantly reduce spore transmission and infection risk.
In conclusion, while sunlight does diminish the viability of ringworm spores, its effectiveness is contingent on duration, intensity, and consistency of exposure. Practical application requires a nuanced understanding of spore resilience and environmental factors. By combining sunlight with other disinfection methods and adopting proactive hygiene practices, individuals can mitigate the risk of ringworm transmission effectively. This approach not only addresses immediate concerns but also fosters long-term environmental management of fungal pathogens.
How Long Can Mold Spores Survive Without Moisture?
You may want to see also
Frequently asked questions
Daylight, particularly sunlight, can help reduce the viability of ringworm spores, but it may not completely kill them. UV rays in sunlight have antifungal properties that can weaken spores over time.
There is no definitive time frame, as it depends on factors like intensity of sunlight, temperature, and humidity. Prolonged exposure (several hours to days) may reduce spore viability, but complete eradication is not guaranteed.
Indoor daylight through windows is less effective than direct sunlight because glass filters out most UV rays, which are responsible for the antifungal effect.
No, daylight is not as effective as disinfectants specifically designed to kill fungi. Disinfectants provide a more reliable and immediate solution for eliminating ringworm spores.
While daylight can help reduce spore viability, it is not a foolproof method for preventing ringworm infections. Proper hygiene, cleaning, and antifungal treatments are more effective preventive measures.